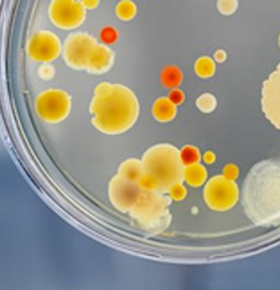
https://polylab-tunisie.pro-caisse.net/wp-content/uploads/2022/11/Microbiologie3.png

Analyse des eaux de différentes sources
L’eau saine est l’élément essentiel pour être en bonne santé. Ne courez donc aucun risque pour vos puits ou autres sources d’eau. Faire analyser votre eau régulièrement pour éviter apparition de contaminations
Parmi les eaux analysées : L’eau potable, Les eaux de puits, Les eaux de piscine, Les eaux de forages pétroliers, Les eaux marines, Les eaux adoucies, Les eaux osmosées, Les eaux de chaudière, Autres sources…

Liens utiles
© 2022 Polylab. All rights reserved
